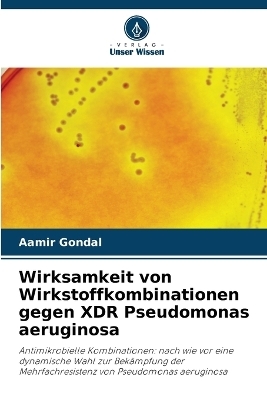
Wirksamkeit von Wirkstoffkombinationen gegen XDR Pseudomonas aeruginosa - Aamir Gondal

Wirksamkeit von Wirkstoffkombinationen gegen XDR Pseudomonas aeruginosa
Seiten
2025
Verlag Unser Wissen
9786206805533 (ISBN)
Verlag Unser Wissen
9786206805533 (ISBN)
- Titel nicht im Sortiment
- Artikel merken
Die sich ständig verändernde Welt der Mikroben stellt die Menschheit vor immer neue Herausforderungen. Die derzeitige Bedrohung durch Mehrfachresistenzen macht das bilaterale Zusammenleben noch kostspieliger und komplizierter. Noch schlimmer ist die reibungslose Ausbreitung dieser Resistenz über Kontinente hinweg aufgrund der leichten Mobilität der Menschen in der globalen Welt. Die Idee der Kombination von Antibiotika wurde genutzt, um die schädlichen Auswirkungen dieser Resistenz zu verlangsamen und zu begrenzen. Pseudomonas-Arten, die maßgeblich zu nosokomialen Infektionen beitragen, reagieren offenbar auf die Kombinationstherapie. Das Ausmaß der Bedrohung erfordert jedoch, dass alle möglichen Wege geprüft und beschritten werden. Die hoffnungsvollen Ergebnisse dieses Projekts und die Feinheiten des Gleichgewichts zwischen Mensch und Mikroben halten den Kampf zwischen den Parteien jedoch offen. Die Leser dieses Buches werden es interessant finden, dass manchmal ein kleiner Durchbruch sehr wertvoll ist und die Motivation aufrechterhält. Noch faszinierender ist die Tatsache, dass Medikamente nur ein Aspekt im Kampf gegen diese Resistenz sind und dass kulturelle und soziale Veränderungen eine entscheidende Rolle spielen werden.
Ich bin derzeit Doktorand an der University of Health Sciences in Lahore. Seit 2003 bin ich beim Gesundheitsministerium der Provinz Punjab tätig und arbeite derzeit an der King Edward Medical University in Lahore. Zu meinen Interessengebieten gehört die Erforschung innovativer molekularer Strategien zur Bekämpfung der vorherrschenden Bedrohung durch Antibiotikaresistenzen.
| Erscheinungsdatum | 03.05.2025 |
|---|---|
| Sprache | deutsch |
| Maße | 152 x 229 mm |
| Gewicht | 109 g |
| Themenwelt | Naturwissenschaften ► Biologie ► Allgemeines / Lexika |
| Naturwissenschaften ► Biologie ► Mikrobiologie / Immunologie | |
| Schlagworte | Antibiotikakombinationen • extensiv resistent • Pseudomonas aeruginosa |
| ISBN-13 | 9786206805533 / 9786206805533 |
| Zustand | Neuware |
| Informationen gemäß Produktsicherheitsverordnung (GPSR) | |
| Haben Sie eine Frage zum Produkt? |
Mehr entdecken
aus dem Bereich
aus dem Bereich
Buch | Softcover (2024)
Wiley-VCH (Verlag)
CHF 55,85
Band 2: Elektrizität, Optik und Wellen
Buch | Softcover (2022)
Wiley-VCH (Verlag)
CHF 55,85
Vom Ursprung der Sexualitat zum modernen Menschen
Buch | Softcover (2025)
UTB (Verlag)
CHF 54,60


